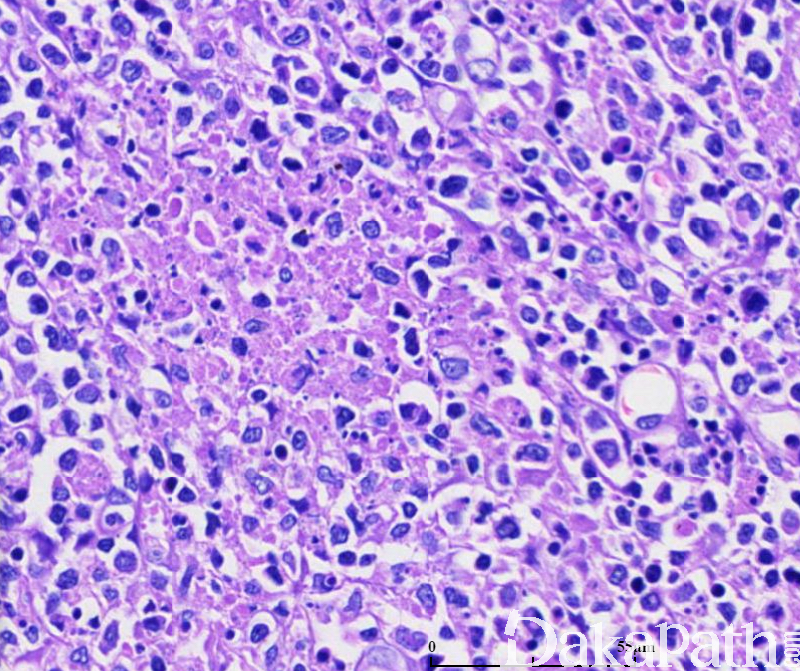

Kikuchi 淋巴结炎
Kikuchi disease
同义词(或曾用名): 组织细胞坏死性淋巴结炎;Kikuchi-Fujimoto disease
概述:
Kikuchi 淋巴结炎由日本学者于 1972 首次描述。呈全球性分布,主要发生与青年,由其是亚州女性。表现为持续、中等大小的颈部淋巴结病,伴发热及触痛,受累淋巴结组织学改变为灶状、界限清楚的副皮质区的坏死性改变。绝大多数病例呈良性和自限性经过,偶有复发或伴有皮肤病变的报道和个别致死病例的报道。病原学不明,有提出弓形虫、EB 病毒、人疱疹病毒(HHV)-6 型和 HHV-8 以及其他病毒的说法,但证据均不充分。
发病部位: 颈部淋巴结
诊断要点:
主要发性于青年人,尤其是亚州青年女性。
颈部淋巴结呈持续性肿大(中等大小),伴触痛、发热和白细胞减少。
组织学改变:
受累淋巴结为灶状、界限清楚的副皮质区坏死性病变,其中见大量的核碎片、散在纤维素沉积和单核细胞聚集,并见大量浆细胞样树突细胞和活化的 T 细胞,浆细胞和中性粒细胞非常少。
淋巴结未受累区域小淋巴细胞背景中散在免疫母细胞,低倍镜下呈斑驳样;可有反应性的淋巴滤泡和高内皮小静脉增生。
有学者将 Kikuchi 分成三种不同的组织学亚型:
增殖型:副皮质区多量免疫母细胞增生,夹杂大的组织细胞、成片的浆细胞样树突细胞及核碎裂小体,组织细胞部分核有切迹、扭曲,及新月型组织细胞(细胞核偏位、弯月形、胞质丰富,内可含核碎片)。
坏死型:为最常见组织学类型。表现为副皮质区不含中性粒细胞浸润的片状坏死,有大量的被单个核细胞围绕的核碎裂碎片,核碎裂碎片可位于组织细胞外或被组织细胞吞噬。
黄色瘤型:此型最少见,可能代表本病的愈合期。可伴有或不伴有坏死,含有大量泡沫状组织细胞,免疫母细胞比其他亚型少。
- 细针穿刺细胞学检查:大量吞噬功能活跃的、新月状的组织细胞,和胞体中等大小、核偏位的浆细胞样树突细胞可提示本病。
免疫组织化学染色:
组织细胞除表达 CD68,还同时表达 MPO、CD43. CD4. CD123;背景细胞以 CD8+T 淋巴细胞为主,B 细胞罕见于病灶。
分子标记:
无 T 或 B 细胞受体基因克隆性重排。
鉴别诊断:
1. 狼疮性淋巴结炎:与 Kikuchi 淋巴结炎的组织学改变有时无法区分,有学者指出两者之间存在相关性。大量中性粒细胞和浆细胞浸润、嗜伊红小体和大片坏死支持 SLE。多数 Kikuchi 淋巴结炎患者缺乏抗核抗体。在诊断 Kikuchi 淋巴结炎时须进行血清学检查,一量 SLE 血清学检查获得阳性结果,则应诊断为狼疮性淋巴结炎。
2. 非霍奇金淋巴瘤(NHL ): 富含免疫母细胞的病例易误诊为非霍奇金淋巴瘤。淋巴结斑片状受累、富含核碎屑、含有新月形组织细胞的混合性细胞浸润,免疫组细胞不表达 B 细胞标记,没有 T 和/或 B 细胞受体基因的克隆性重排等特点支持 Kikuchi 淋巴结炎。
← Kimura病 Castleman病 →